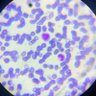
kuchbhikotecha's profile picture. PGY3 MD Pathology | BJMC, Ahmedabad

你可能會喜歡
I would like to bring in notice the Injustice happening to the resident doctors in BJMC and the pressure given by the authorities on the doctors who suffered for no reason Respected @sanghaviharsh ji I request you to pls ensure your authorities do not misbehave with the doctors


My parents visited Kashmir 2 years back as it was my mom’s lifelong dream but before departure they joked about never being able to return so we must know all the bank details and property details Today that joke became reality for some people 💔 RIP Pahalgam victims 😔
Dear @TRAI can we pls stop those pre recorded audio regarding cyber safety before placing calls??? It's really annoying and frustrating while trying to make an emergency call
Hospital Rule no 1 : Baat kitni bhi choti ho , Documentation jarur karo.
Are there any people here going to take up psychiatry ?
Now thats neet pg registration have started My little advice to fellow aspirants Please please please dont select this field as an option Psychiatry is a very unique branch with its own challenges and you need to love it to see its uniqueness
Why does my dept gives me saad bahu drama feels seniors creating unnecessary drama and suddenly being so lovey dovy to juniors and changing rules for them I mean padhlo yar thode time main exam hai 😅
This Ganesh Pandal with a strong symbolic meaning for RG KAR justice is from Hyderabad Whosoever made it deserves applaud 👏🏻

Senior doctors reassure junior residents on the protest site(Swastha Bhawan,Salt lake Sector V,Kolkata) that they’ll stop all OPD services if even one of the protesting junior residents are suspended🔥 These moments instill faith in our fraternity. We want justice✊🏻…
Why the hell any reservation exist after doing MBBS?? No one can uplift you in life if Tag of doctor can’t.

United States 趨勢
- 1. #StrangerThings5 99.9K posts
- 2. Thanksgiving 605K posts
- 3. Afghan 231K posts
- 4. National Guard 587K posts
- 5. Gonzaga 7,123 posts
- 6. holly 43.1K posts
- 7. #AEWDynamite 20.2K posts
- 8. robin 58.9K posts
- 9. Michigan 72.8K posts
- 10. Dustin 83K posts
- 11. #Survivor49 2,839 posts
- 12. Rahmanullah Lakanwal 88.2K posts
- 13. Tini 6,658 posts
- 14. Erica 11.4K posts
- 15. #GoAvsGo 1,200 posts
- 16. Kevin Knight 2,495 posts
- 17. Dusty May N/A
- 18. Bill Kristol 7,251 posts
- 19. Cease 28.5K posts
- 20. Doris Burke N/A
你可能會喜歡
-
 Dr. Ankur Mishra
Dr. Ankur Mishra
@akm_ipl -
 Dr. Meenakshi Bhatia
Dr. Meenakshi Bhatia
@as_klepian -
 Dr. Meet Mehta
Dr. Meet Mehta
@Meet_Mehta_1208 -
 Dr. Preksha Luthra
Dr. Preksha Luthra
@prekaaaaaa -
 Dr.Pareek_06
Dr.Pareek_06
@DrPareek_06 -
 Pratyusha
Pratyusha
@AnotherParadox0 -
 Dr Shubhi Jain
Dr Shubhi Jain
@DrShubhiJain1 -
 Preety 🇮🇳
Preety 🇮🇳
@Preety44455 -
 Dr.She
Dr.She
@drshe227 -
 Dr. Soumya Tripathi 🇮🇳
Dr. Soumya Tripathi 🇮🇳
@SoumyaTrp -
 Darshni Kotecha
Darshni Kotecha
@kuchbhikotecha -
 Akanksha Nag
Akanksha Nag
@AkankshaNag6 -
 bioluminescence
bioluminescence
@colorful_sclpel -
 Dr. Shubhangi Seth🦋
Dr. Shubhangi Seth🦋
@notmethenwho02 -
 Ayushi 🪷
Ayushi 🪷
@ayushiii07
Something went wrong.
Something went wrong.